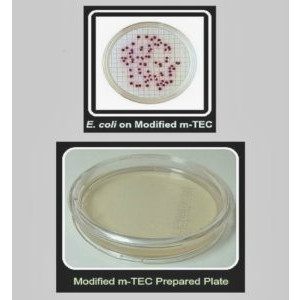
Aquaplates Modified m-TEC Prepared Media Plates, EPA Approved for NPDES Reporting (12 per Sleeve)
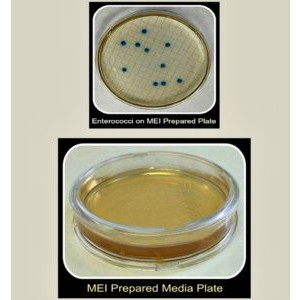
Aquaplates MEI Media Method USEPA 1600 for Enterococcus, EPA Approved for NPDES Reporting (12 per Sleeve)

-
Products
- ANALYZER CONSUMABLES
- AMK GLASS (LAB GLASSWARE)
- BAGS
- BAILERS
- BEAKERS
- BOTTLES (GLASS)
- BOTTLES (PLASTIC)
- CARBOYS, DRUMS & PAILS
- CENTRIFUGE TUBES
- CHEMICALS
- CHROMATOGRAPHY (VIALS & CAPS)
- CONTAINERS
- COOLERS
- CRYOGENIC VIALS
- CYLINDERS
- DIGESTION TUBES
- EQUIPMENT
- FILTRATION PRODUCTS
- FLASKS
- FUNNELS
- GAS SAMPLING BAGS
- GLOVES
- GROUNDWATER FILTERS
- INOCULATION LOOPS
- MEDICAL LAB SUPPLIES
- MICROSCOPE SLIDES
- MISCELLANEOUS
- MULTI-WELL PLATES
- PCR TUBES
- PETRI DISHES
- PIPETTES
- PIPETTE TIPS
- PIPETTORS
- POLYAIR PRODUCTS
- RACKS
- SAMPLERS, SCOOPS, SPOONS, SPATULAS & DIPPERS
- SOIL SAMPLING
- STORAGE VIALS & CAPS
- SYRINGES
- TEST TUBES, VIALS, AND CAPS
- TUBING
- VOA VIALS
- WEIGHING DISHES
- About Us
- Contact Us
- My Account
- Clearance
-
Products
- ANALYZER CONSUMABLES
- AMK GLASS (LAB GLASSWARE)
- ASTM & Petrochemical
- Burets
- Centrifuge Tubes
- Condensers
- Cylinders
- Distillation
- Evaporation
- Extraction
- Flasks
- Funnels
- QUARTZ
- Sparge Tubes
- Specific Gravity Testing
- BAGS
- BAILERS
- BEAKERS
- BOTTLES (GLASS)
- BOTTLES (PLASTIC)
- PFAS Bottles
- Assembled Only
- Certified Bottles
- Fuel Sampling Bottles
- Lab Bottles
- Nalgene
- CARBOYS, DRUMS & PAILS
- CENTRIFUGE TUBES
- CHEMICALS
- CHROMATOGRAPHY (VIALS & CAPS)
- CONTAINERS
- COOLERS
- CRYOGENIC VIALS
- CYLINDERS
- DIGESTION TUBES
- EQUIPMENT
- FILTRATION PRODUCTS
- FLASKS
- FUNNELS
- GAS SAMPLING BAGS
- GLOVES
- GROUNDWATER FILTERS
- INOCULATION LOOPS
- MEDICAL LAB SUPPLIES
- MICROSCOPE SLIDES
- MISCELLANEOUS
- MULTI-WELL PLATES
- PCR TUBES
- PETRI DISHES
- PIPETTES
- PIPETTE TIPS
- PIPETTORS
- POLYAIR PRODUCTS
- RACKS
- SAMPLERS, SCOOPS, SPOONS, SPATULAS & DIPPERS
- SOIL SAMPLING
- STORAGE VIALS & CAPS
- SYRINGES
- TEST TUBES, VIALS, AND CAPS
- TUBING
- VOA VIALS
- WEIGHING DISHES
- About Us
Disposable or reusable petri dish surfaces come non-treated or treated for cell attachment. Tight fitting lids protect sample from contamination and may be vented.
Product was successfully added to your shopping cart.
PETRI DISHES
Featured
COPYRIGHT 2025 GREENWOOD PRODUCTS INC. |CAREERS
|SHIPPING & RETURNS
|PRIVACY POLICY
|TERMS OF USE